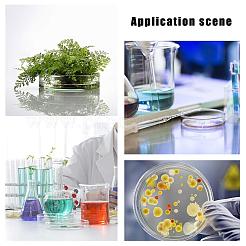
Поделки комплекты DIY-OC0001-50

- 0
- 0
- Days
- 0
- 0
- :
- 0
- 0
- :
- 0
- 0
-
Железные Крокодил, стальными проволоками, карта примечание фотография...
Варианты:US $18.70 US $18.70 / 500 шт. Размер Упаковки: 500 шт.
Миним. цена US $0.04/ шт.
НИЖНЯЯ ЦЕНА на Pandawhole
-
Абс публичные наклейки, для дверной фурнитуры знак, Потяните Нажмите...
US $2.80 / 5.00 US $2.80 / 1 Пакет -44% Размер Упаковки: 1 Пакет
-
Уф-защищенный и водонепроницаемый алюминиевый предупреждающие знаки...
Самая низкая цена
US $1.65 / 3.06 US $1.65 / 2 шт. -46% Размер Упаковки: 2 шт.
Миним. цена US $0.83/ шт.
-
Плечевые ремни из искусственной кожи аккордеона, с регулируемыми...
US $12.92 US $12.92 / 1 Пара Размер Упаковки: 1 Пара
-
Наклейки-знаки из нержавеющей стали 430, с двусторонней липкой лентой...
US $1.79 / 3.19 US $1.79 / 1 набор -44% Размер Упаковки: 1 набор
-
Штуцер переборки пвх, для дождевых бочек, аквариумы, резервуары для...
US $1.95 / 2.83 US $1.95 / 4 наборов -31% Размер Упаковки: 4 наборов
Миним. цена US $0.49/ набор
Поторопитесь, осталось мало!
-
Уф-защищенный и водонепроницаемый алюминиевый предупреждающие знаки...
Самая низкая цена
US $1.66 / 2.82 US $1.66 / 1 шт. -41% Размер Упаковки: 1 шт.
-
2" фут светоотражающая предупреждающая лента желто-красная...
US $3.08 / 5.50 US $3.08 / 1 Рулон -44% Размер Упаковки: 1 Рулон
-
Записки и держатели для заметок из смолы, Красное сердце, платина...
US $3.86 / 5.59 US $3.86 / 2 шт. -31% Размер Упаковки: 2 шт.
Миним. цена US $1.93/ шт.
-
Пластиковые коробки для сбора, коробки для монет, квадратный, чёрные...
Варианты:US $2.57 US $2.57 / 9 шт. Размер Упаковки: 9 шт.
Миним. цена US $0.29/ шт.
Поторопитесь, осталось мало!
-
Уф-защищенный и водонепроницаемый алюминиевый предупреждающие знаки...
US $1.19 / 2.65 US $1.19 / 1 шт. -55% Размер Упаковки: 1 шт.
Поторопитесь, осталось мало!
-
Портативный компас из алюминиевого сплава, открытый компас, платина...
US $25.50 US $25.50 / 50 шт. Размер Упаковки: 50 шт.
Миним. цена US $0.51/ шт.
НИЖНЯЯ ЦЕНА на Pandawhole
-
Пластиковые мешки, прямоугольные, белые, 170x108 мм
US $2.04 US $2.04 / 4 шт. Размер Упаковки: 4 шт.
Миним. цена US $0.51/ шт.
-
Уф-защищенный и водонепроницаемый алюминиевый предупреждающие знаки...
Самая низкая цена
US $3.24 / 6.12 US $3.24 / 4 шт. -47% Размер Упаковки: 4 шт.
Миним. цена US $0.81/ шт.
-
Пластиковая папка мел, письменные принадлежности для офиса, голубой...
US $1.69 US $1.69 / 27 шт. Размер Упаковки: 27 шт.
Миним. цена US $0.06/ шт.
Поторопитесь, осталось мало!
-
Уф-защищенный и водонепроницаемый алюминиевый предупреждающие знаки...
US $0.90 / 2.01 US $0.90 / 1 шт. -55% Размер Упаковки: 1 шт.
Поторопитесь, осталось мало!
-
Наборы слоганов своими руками, с социальным полом и наклейками с...
US $9.08 US $9.08 / 1 набор Размер Упаковки: 1 набор
-
Уф-защищенный и водонепроницаемый алюминиевый предупреждающие знаки...
Самая низкая цена
US $2.12 / 3.71 US $2.12 / 1 шт. -43% Размер Упаковки: 1 шт.
-
Пластиковая папка мел, письменные принадлежности для офиса, красные...
US $1.19 US $1.19 / 19 шт. Размер Упаковки: 19 шт.
Миним. цена US $0.06/ шт.
Поторопитесь, осталось мало!
-
Пластиковая выдвижная катушки значок, держателей карт, с железной...
US $2.87 / 5.21 US $2.87 / 1 набор -45% Размер Упаковки: 1 набор
-
Уф-защищенный и водонепроницаемый алюминиевый предупреждающие знаки...
US $3.69 - 4.61 Размер Упаковки: 1 шт.
Миним. цена US $3.69/ шт.
-
Черный нескользящий пенопластовый коврик для мебели, с клеем...
US $8.45 US $8.45 / 35 шт. Размер Упаковки: 35 шт.
Миним. цена US $0.24/ шт.
-
Записки и держатели для заметок из смолы, Красное сердце, платина...
US $8.25 US $8.25 / 4 шт. Размер Упаковки: 4 шт.
Миним. цена US $2.06/ шт.
Поторопитесь, осталось мало!
-
Пластиковый зажим-на выдвижных значки держателей, Держатели тег карт...
US $19.04 US $19.04 / 100 шт. Размер Упаковки: 100 шт.
Миним. цена US $0.19/ шт.
НИЖНЯЯ ЦЕНА на Pandawhole
-
Поделки комплекты, с чашкой Петри для культивирования с высоким...
Самая низкая цена
US $2.84 / 5.07 US $2.84 / 1 набор -44% Размер Упаковки: 1 набор
-
Сплав выдвижной катушка значок, держателей карт, с пластиковой и...
US $1.49 - 1.86 Размер Упаковки: 1 шт.
Миним. цена US $1.49/ шт.
-
Уф-защищенный и водонепроницаемый алюминиевый предупреждающие знаки...
US $1.50 / 3.34 US $1.50 / 2 шт. -55% Размер Упаковки: 2 шт.
Миним. цена US $0.75/ шт.
Поторопитесь, осталось мало!
-
Уф-защищенный и водонепроницаемый алюминиевый предупреждающие знаки...
US $2.78 / 6.19 US $2.78 / 1 шт. -55% Размер Упаковки: 1 шт.
Поторопитесь, осталось мало!
-
Катушка для белья, держателей карт, с зажимом из кожи аллигатора...
US $1.92 / 3.44 US $1.92 / 1 набор -44% Размер Упаковки: 1 набор
-
Уф-защищенный и водонепроницаемый алюминиевый предупреждающие знаки...
US $1.74 / 5.43 US $1.74 / 1 шт. -68% Размер Упаковки: 1 шт.
Поторопитесь, осталось мало!
-
Патч для ремонта стен из алюминия, ремонт самоклеящихся пластырей, для...
US $7.07 US $7.07 / 13 шт. Размер Упаковки: 13 шт.
Миним. цена US $0.54/ шт.
Поторопитесь, осталось мало!
-
Плоскогубцы для удаления скоб из нержавеющей стали, съемник для...
US $4.23 US $4.23 / 1 набор Размер Упаковки: 1 набор
НИЖНЯЯ ЦЕНА на Pandawhole
-
Диплом сертификат, синяя граница, чистый лист бумаги формата Letter...
US $10.88 US $10.88 / 40 Листов Размер Упаковки: 40 Листов
Миним. цена US $0.27/ Лист
Поторопитесь, осталось мало!
-
Железные скрепки в форме книги, милые скрепки, забавные закладки...
US $3.06 US $3.06 / 50 шт. Размер Упаковки: 50 шт.
Миним. цена US $0.06/ шт.
НИЖНЯЯ ЦЕНА на Pandawhole
-
Знак уведомления о смоле, квадратный с открытым, белые, 10x10x0.35 см
US $6.80 US $6.80 / 1 шт. Размер Упаковки: 1 шт.
-
Держатели для заметок из смолы с квадратным основанием, со стальной...
US $3.02 / 5.50 US $3.02 / 6 шт. -45% Размер Упаковки: 6 шт.
Миним. цена US $0.50/ шт.
-
Наборы офисных инструментов, с прозрачным пружинным настольным...
US $3.66 / 10.16 US $3.66 / 1 набор -64% Размер Упаковки: 1 набор
Поторопитесь, осталось мало!
-
Металлические маркеры рисуют ручки, ручка для подписи маркера граффити...
Самая низкая цена
US $2.04 / 3.71 US $2.04 / 1 набор -45% Размер Упаковки: 1 набор
-
Пластиковый депрессор языка, светло-синий, 147.5x19x1.6 мм
US $0.11 US $0.11 / 1 шт. Размер Упаковки: 1 шт.
Поторопитесь, осталось мало!
-
Офисная больница из пвх поставляет специальную ручку, разноцветные...
Самая низкая цена
US $1.52 / 2.77 US $1.52 / 1 набор -45% Размер Упаковки: 1 набор
-
Уф-защищенный и водонепроницаемый алюминиевый предупреждающие знаки...
Самая низкая цена
US $1.71 / 3.06 US $1.71 / 2 шт. -44% Размер Упаковки: 2 шт.
Миним. цена US $0.86/ шт.
-
Изоляционные листы из пробки, прямоугольные, для каботажного судна...
US $1.45 - 1.81 Размер Упаковки: 2 шт.
Миним. цена US $0.73/ шт.
-
Силиконовые перчатки для мытья посуды, мыть посуду, чистя перчатки, с...
US $3.40 US $3.40 / 1 Пара Размер Упаковки: 1 Пара
-
Алюминиевые бланки, для лазерной гравировки визитных карточек на заказ...
US $8.28 US $8.28 / 50 Листов Размер Упаковки: 50 Листов
Миним. цена US $0.17/ Лист
-
Калька натуральная полупрозрачная сульфатная бумага, серый...
US $0.41 US $0.41 / 10 Листов Размер Упаковки: 10 Листов
Миним. цена US $0.04/ Лист
-
Пластиковая выдвижная катушки значок, держателей карт, с железной...
US $0.95 US $0.95 / 1 шт. Размер Упаковки: 1 шт.
Поторопитесь, осталось мало!
-
Пластиковые клей бутылки, портативный складной силиконовый воронка...
US $8.67 US $8.67 / 1 набор Размер Упаковки: 1 набор
-
Алюминиевые бланки, для лазерной гравировки визитных карточек на заказ...
Мин. заказ: 2Самая низкая цена
US $2.74 / 10.13 US $2.74 / 1 набор -73% Размер Упаковки: 1 набор
Поторопитесь, осталось мало!
-
12 шт. металлические маркеры, краски, ручки, многоцветная ручка для...
Самая низкая цена
US $2.43 / 4.42 US $2.43 / 1 Коробка -45% Размер Упаковки: 1 Коробка
-
Железные карты, Рисование штифтов, со смолой, Пчелы, для фото стены...
US $2.94 / 5.34 US $2.94 / 1 Коробка -45% Размер Упаковки: 1 Коробка
-
Пластиковые карты, Рисование штифтов, Флаговый указатель, Офисные и...
US $7.56 US $7.56 / 556 шт. Размер Упаковки: 556 шт.
Миним. цена US $0.01/ шт.
Поторопитесь, осталось мало!
-
Пластиковые коробки для сбора, коробки для монет, квадратный, чёрные...
US $9.61 US $9.61 / 1 набор Размер Упаковки: 1 набор
-
Компас из алюминиевого сплава, плоско-круглые, чёрные, 44x9 мм
US $13.60 US $13.60 / 20 шт. Размер Упаковки: 20 шт.
Миним. цена US $0.68/ шт.
НИЖНЯЯ ЦЕНА на Pandawhole
-
Фломастер, сумка для хранения ручки, для мальчиков девочек, школьный...
US $11.42 US $11.42 / 20 шт. Размер Упаковки: 20 шт.
Миним. цена US $0.57/ шт.
Поторопитесь, осталось мало!
-
Прозрачные стеклянные пробирки, с пробками, для научных экспериментов...
US $0.92 US $0.92 / 5 шт. Размер Упаковки: 5 шт.
Миним. цена US $0.18/ шт.
Поторопитесь, осталось мало!
-
Деревянные карты, Рисование штифтов, i-образная головка, с контактом...
US $1.17 - 1.46 Размер Упаковки: 50 шт.
Миним. цена US $0.02/ шт.
-
Прозрачные стеклянные пробирки, с пробками, для научных экспериментов...
US $1.23 - 1.54 Размер Упаковки: 5 шт.
Миним. цена US $0.25/ шт.
-
Скрепки из чугуна, милые скрепки, забавные закладки маркировочные...
US $4.05 US $4.05 / 50 шт. Размер Упаковки: 50 шт.
Миним. цена US $0.08/ шт.
-
Прозрачный пластиковый ящик для хранения ручек для татуировок, коробка...
Мин. заказ: 5US $1.76 / 3.14 US $1.76 / 12 шт. -44% Размер Упаковки: 12 шт.
Миним. цена US $0.15/ шт.
-
Пластиковые коробки для сбора, коробки для монет, квадратный, чёрные...
US $0.27 US $0.27 / 1 шт. Размер Упаковки: 1 шт.
Поторопитесь, осталось мало!
Диапазон цен
$ ~ $
Диапазон скидок
% ~ %
- Все со скидкой
- 20%-40%
- 40%-60%
- 60% +
- APP
- ПОМОЩЬ
- Стоимость доставки
- Отслеж-ивание
- Top
Подтвердить
Пожалуйста, обратите внимание
Поиск по Картинке
-

-
1. Перетащите изображение или
2. Вставьте изображение Ctrl/Cmd + V
-
- ИЛИ
PANDA СВОЕВР. ОБСЛ.
При товарах на предзаказе, срок выполнения которых превышает 15 рабочих дней (без учета срока доставки), будет выплачена компенсация в размере 3 долларов США за каждый товар. Подробнее >>
Без скидки на доставку
Этот товар не подходит для скидок на доставку, вам нужно будет оплатить полную стоимость доставки.
Ограниченное количество
Это товар ограничен в наличии. Закажите как можно скорее, пожалуйста.
LEAD-FREE BRILLIANCE
Продукция Preciosa® с символом Lead-Free Brilliance содержит менее 0,009% свинца (<90 ppm) и изготавливается в соответствии с высочайшими стандартами экологического и устойчивого производства. Эта продукция премиум-класса соответствует самым строгим отраслевым стандартам и международным сертификатам безопасности.
Без свинца
Общее содержание свинца (Pb) в продукте соответствует авторитетным стандартам содержания свинца, изложенным в регламенте REACH.
Без никеля
Продукты соответствуют авторитетным стандартам содержания никеля, установленным в регламенте REACH.
Без кадмия и без свинца
Общее содержание кадмия (Cd) и свинца (Pb) в продукте соответствует авторитетным стандартам содержания кадмия и свинца, установленным в регламенте REACH.
Самая низкая цена
Основано на самой низкой публичной промо-цене за последние 180 дней.

iOS APP
iOS APP Google Play
Google Play
